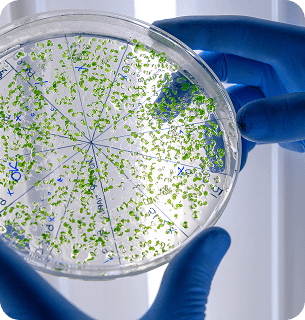
нормализация микрофлоры и уменьшение воспалений

PRP-терапия (плазмотерапия)
от 37 500 ₽ до 48 000 ₽
Запись на прием
Лечение в GrandWoman, это:
GrandWoman
Об услуге
GrandWoman
PRP-терапия – современный метод регенеративной медицины, который применяется в том числе в области интимной зоны. Методика основана на использовании плазмы, обогащенной тромбоцитами. Процедура помогает запустить естественные процессы восстановления тканей без использования искусственных препаратов.
В клинике GrandWoman в Санкт-Петербурге плазмотерапия проводится опытными врачами-специалистами в области гинекологии и эстетической медицины.
Суть метода
PRP плазмотерапия – это инъекционная терапия, при которой используется собственная венозная кровь. Ее забирают у пациентки, а затем обрабатывают в центрифуге. Цель – получение Platelet Rich Plasma (PRP), то есть плазмы, обогащенной тромбоцитами.
Тромбоциты способны:
- стимулировать регенерацию тканей;
- улучшать микроциркуляцию;
- активировать синтез коллагена;
- усиливать питание клеток.
Плазмотерапия часто используется в косметологии (для кожи лица и тела), ортопедии (при лечении суставов), а также в гинекологии. В отличие от синтетических препаратов, терапия PRP использует собственный биоматериал пациента, обеспечивая полную совместимость.
Применение PRP-терапии в гинекологии
В гинекологии PRP применяется для лечебных и для восстановительных целей.
Основные направления:
- восстановление слизистой после воспалительных процессов или возрастных изменений;
- поддержка при хронических гинекологических заболеваниях;
- улучшение состояния тканей после родов;
- лечение эрозии шейки матки;
- коррекция возрастных изменений;
- смягчение рубцов;
- подготовка к беременности и программам ЭКО;
- поддержка функции яичников.
PRP-терапия может использоваться как самостоятельный метод, так и в составе комплексного лечения или эстетических процедур.
Показания для интимного плазмолифтинга
Интимный плазмолифтинг с применением PRP рекомендуется при:
- утрачивании эластичности;
- истончении слизистой;
- появлении сухости и дискомфорта;
- уменьшении чувствительности;
- возрастных проявлениях;
- нарушениях микроциркуляции.
PRP-плазмотерапия помогает активировать процессы омоложения и восстановления тканей естественным образом – за счет собственных ресурсов организма.
Противопоказания
Плазмотерапия безопасна, но как любая другая методика имеет некоторые ограничения:
- острые инфекции;
- онкозаболевания;
- нарушения свертываемости крови;
- тяжелые системные патологии;
- беременность.
Перед назначением процедуры доктор проводит гинекологический осмотр и оценивает состояние здоровья пациентки.
Как проходит процедура плазмолифтинга
Плазмотерапия проводится амбулаторно в условиях клиники.
Этапы:
- Забор небольшого количества венозной крови.
- Обработка в центрифуге.
- Получение PRP
- Инъекционное введение плазмы в выбранные зоны.
Процедура занимает около 20–30 минут. Обычно обезболивание не требуется, но по желанию используются местные анестетики для полного комфорта.
Курс плазмотерапии интимной зоны, как правило, включает 3–10 сеансов с перерывом 7–10 дней. Точное количество процедур зависит от состояния тканей и цели терапии. Иногда для усиления эффекта PRP сочетается с другими методиками – например, липофилингом больших половых губ или интимной контурной пластикой.
Подготовка к процедуре
Серьезные подготовительные меры не требуются. Перед плазмотерапией рекомендуется:
- обратиться к гинекологу за консультацией;
- сдать базовые анализы крови;
- исключить прием антикоагулянтов;
- избегать алкоголя за 1–2 дня.
Реабилитационный период
После процедуры возможна легкая отечность или чувствительность в месте проведения инъекций. Это нормальная реакция. Полное восстановление занимает от 5 до 10 дней.
Рекомендации после проведения процедуры:
- воздержаться от интимной близости – от 6 дней;
- отказаться от сауны, бани, горячей ванны и бассейна – в первые 2 дня;
- соблюдать рекомендации врача;
- приходить на контрольный осмотр.
В клинике GrandWoman в Санкт-Петербурге PRP-терапия проводится по современным стандартам безопасности. Методика помогает мягко и естественно активировать процессы восстановления и поддержать женское здоровье. Если вас интересует интимная плазмотерапия, запишитесь на консультацию специалиста по эстетической гинекологии.
Эффект от процедуры:
-
улучшение чувствительности интимной зоны
-
устранение сухости, жжения и микротрещин
-
стимуляция выработки коллагена, улучшение эластичности тканей
-
повышение тонуса и упругости слизистой
-
снижение симптомов стрессового недержания мочи
-
ускорение восстановления после родов и хирургических вмешательств
-
нормализация микрофлоры и уменьшение воспалений
-
Команда врачей
GrandWoman
Пакетные предложения
PRP-терапия (яичников)
- PRP-терапия (яичников) - 18 500 ₽
- Анестезиологическое пособие (30 мин) - 14 000 ₽
- Госпитализация (до 6 часов) - 5 000 ₽
Итого: 37 500 ₽
PRP-терапия (внутриматочная и внутривлагалищная)
- PRP-терапия (внутриматочная и внутривлагалищная) - 11 000 ₽
- Гистероскопия (диагностическая) - 15 000 ₽
- Анестезиологическое пособие (30 мин) - 14 000 ₽
- Госпитализация (до 6 часов) - 5 000 ₽
- Профилактика ВТЭО - 3 000 ₽
Итого: 48 000 ₽
Частые вопросы
GrandWoman
Что такое PRP-терапия интимной зоны?
Это инъекционная процедура, при которой используется собственная плазма крови, обогащённая тромбоцитами — они запускают активное восстановление тканей.Кому показана процедура?
Женщинам с сухостью, сниженной чувствительностью, микротравмами, послеродовыми изменениями, хроническими воспалениями или недержанием мочи. Особенно актуально в период менопаузы.Насколько безопасна процедура?
Процедура абсолютно безопасна, так как используется собственный биоматериал пациентки. Риск аллергии или отторжения отсутствует.Больно ли это?
Перед инъекцией применяется местная анестезия. Процедура переносится легко и занимает около 30 минут.Сколько нужно процедур?
Часто заметный эффект уже после 1 сеанса. Для стойкого результата может потребоваться курс из 2–3 процедур с интервалом 3–4 недели.Как быстро проявляется эффект?
Уже через несколько дней снижается сухость и улучшается чувствительность. Максимальный эффект — через 2–4 недели после процедуры.Можно ли совмещать PRP с другими процедурами?
Да, плазмотерапия усиливает эффект интимного лазерного омоложения, контурной пластики, биоревитализации.Сколько стоит PRP-терапия?
Цена зависит от количества процедур и объема введения плазмы. Предварительный прайс есть на нашем сайте. Персональную стоимость врач рассчитывает после консультации в клинике.Будет ли больно?
Процедура переносится комфортно большинством пациенток. При необходимости используется местная анестезия.Сколько процедур PRP понадобится для достижения эффекта?
Обычно курс включает 3–10 процедур. Количество определяется индивидуально.Можно ли совмещать PRP с другими процедурами?
Да. Плазмотерапию часто комбинируют с другими методиками для усиления результата.Насколько безопасна плазмотерапия?
Методика основана на использовании собственного биоматериала пациента, поэтому риск осложнений и аллергических реакций сведен к минимуму.
Статьи
GrandWoman
Лицензии и сертификаты
GrandWoman